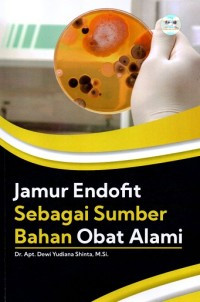
Jamur Endofit sebagai Sumber Bahan Obat Alami

Detail Cantuman
Pencarian Spesifik
Text
Jamur Endofit sebagai Sumber Bahan Obat Alami
Tidak Tersedia Deskripsi
Ketersediaan
| mipa240140h | 635.8 SHI j | Fakultas Matematika dan Ilmu Pengetahuan Alam (FMIPA) (Rak 600) | Tersedia |
Informasi Detail
| Judul Seri |
-
|
|---|---|
| No. Panggil |
635.8 SHI j
|
| Penerbit | Deepublish : Yogyakarta., 2021 |
| Deskripsi Fisik |
vi,43hal;23cm
|
| Bahasa |
Indonesia
|
| ISBN/ISSN |
978-623-02-2645-8
|
| Klasifikasi |
635.8
|
| Tipe Isi |
-
|
| Tipe Media |
-
|
|---|---|
| Tipe Pembawa |
-
|
| Edisi |
-
|
| Subjek | |
| Info Detail Spesifik |
-
|
| Pernyataan Tanggungjawab |
-
|
Versi lain/terkait
Tidak tersedia versi lain
